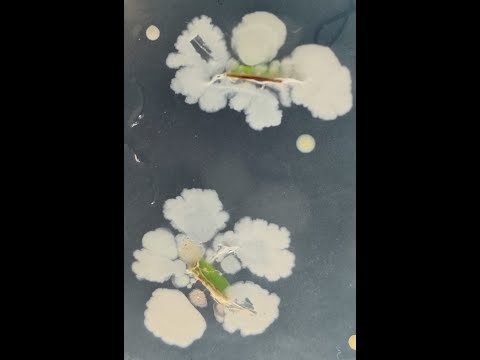

Barcode Biotechnology
Endophyte Isolation FAILS: What Went Wrong? & What We Learned?
17:29

Barcode Biotechnology
How to get isolated bacterial colony in last quadrant? - Introducing 6-3 cascade streaking!
30:10

Barcode Biotechnology
1000 Barcode Initiative - various services and research internships offered by Barcode Biotechnology
22:08

Barcode Biotechnology
Webinar on DNA Barcoding
45:07

Barcode Biotechnology
Summer Internship in DNA Barcoding and Barcode Analysis!
4:44

Barcode Biotechnology
How to prepare species identification report?
15:25

Barcode Biotechnology
Reverse complementing using BioEdit
15:23

Barcode Biotechnology
Sanger's DNA Chromatogram Interpretation
23:21

Barcode Biotechnology
Pairwise Distance Analysis
8:10

Barcode Biotechnology
Trouble shooting - phylogram construction
14:48

Barcode Biotechnology
Introduction to Sanger's DNA Sequence Analysis
24:57